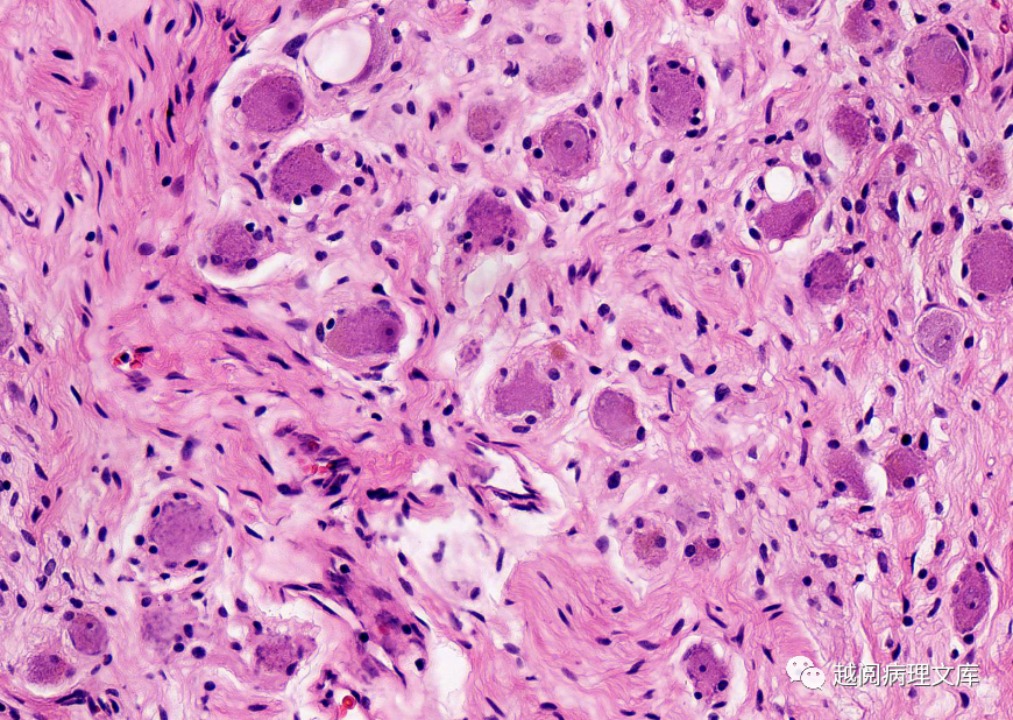

这个颈部肿块,你考虑是什么?
https://mp.weixin.qq.com/s/hTYt5_lDuhoC2ZC0aNzSEg
病例回顾
患者,张某某,男,48 岁,因左侧颈部肿块 1 月余来院就诊,无其他不适症状。
专科检查:左侧颈部触及一大小约 4.0cm×2.0cm 肿块,边界清,活动度一般,质地较软,无压痛,现查浅表肿物超声。
超声所见:左侧颈部皮下可见实性低回声包块,大小约 4.0cm×2.0cm×2.1cm,边界清,形态稍饱满,内回声不均匀,可见散在点状强回声,似有包膜(图 1),横切面扫查此包块位于左侧颈总动脉与左侧锁骨下静脉之间(图 2),CDFI:其内可见少量血流信号(图 3)。
超声提示:左侧颈部实性低回声包块(考虑神经源性肿瘤?请结合其他相关检查)

图1 包块二维声像图
图2 横切面扫查:包块位于 LCCA 与 LSCV 之间
图3 包块内探及少量血流信号
术后病理
(左侧颈部肿物):符合节细胞神经瘤。
免疫组化标记:S-100(+)、NSE(+)、Vim(+),CD34(-)、EMA(-),Ki67(+约1%)。
病例讨论
节细胞神经瘤 (ganglioneuroma,GN),又称为神经节细胞瘤,是一种来源于神经嵴的罕见良性肿瘤,起源于交感神经节细胞,包括交感神经节链。肿块周围有纤维性包膜,内含不同数量的黏液样基质。约占周围神经组织肿瘤的2%~3%。
1.流行病学
(1)本病可发生于任何年龄,40岁以下多见,发病率无性别及地域的差异性。
(2)发病部位:后纵隔、腹膜后、肾上腺、颈部、皮肤、膀胱、前列腺、睾丸旁、卵巢和胃肠道。
(3)节细胞的胞质丰富,呈淡嗜伊红色,核大,圆形或椭圆形,染色质淡,内含1~3个核仁。
2.病理特征
镜下其主要由大量的黏液基质和一些雪旺氏细胞、神经节细胞构成,由于大量黏液基质的存在,所以质地较柔软,沿周围组织器官间隙呈嵌入性生长,肿瘤较大时,邻近血管可被包埋或受压移位,但无狭窄、闭塞等受侵征象,很少有出血、坏死或囊变,部分可有斑点状、沙粒状钙化。
3.临床表现
患者一般无明显临床症状,常在体检或者触摸中被发现。
4.超声特征
(1)以低回声实性肿块为主,形态各异,包膜光整,边界清晰,部分瘤体内部可见伴彗星征的团状强回声,提示肿块内含黏液基质成分。
(2)肿块较大时,呈伪足状或泪滴状伸入血管周围,包绕部分或全部血管,但与血管之间边界清楚。
(3)节细胞神经瘤多为乏血供肿瘤,瘤体内部血供较稀疏。
5.鉴别诊断
(1)神经鞘瘤:有典型 “鼠尾征”,易发生变性坏死,甚至表现为囊性肿瘤。
(2)神经纤维瘤:多表现为边界清晰光滑,内部低回声,无包膜,后方有回声增强,内部血流信号较丰富。
(3)神经母细胞瘤:以婴幼儿多见,肿瘤恶性程度高,肿瘤内部回声不均,可见粗大钙化。
6.治疗
首选手术切除,一般预后较好,不易复发和转移。
